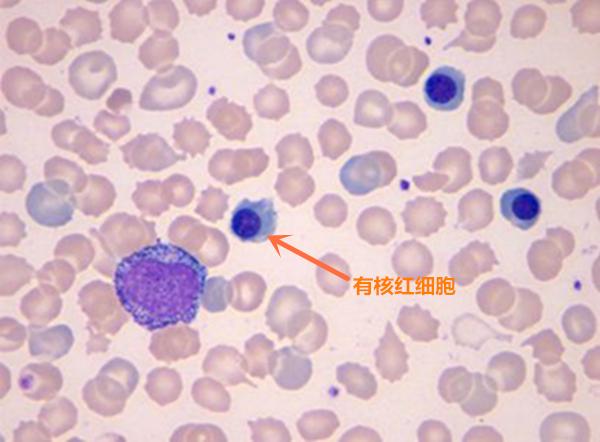

血常规报告单中除了含有红细胞、白细胞、血小板及其相关参数这些项目外,还有一个容易被忽视的项目有核红细胞。

成熟红细胞无细胞核,成分是蛋白质和铁,有运输氧的功能。有核红细胞是未脱去细胞核的未成熟红细胞。
生理性:
在出生1周之内的新生儿外周血中可见到少量。
病理性:
成人外周血中出现有核红细胞均属病理现象。可见于以下:
一、血液病:
(一)增生性贫血:常见于各种贫血,急性失血性贫血、巨幼红细胞性贫血、严重的低色素性贫血。因红细胞大量破坏,机体相对缺氧,导致促红细胞生成素水平增高,骨髓经系增生,除了网织红细胞大量入血外,还会以出现晚幼红细胞或中幼红细胞为多见。外周血中出现有核红细胞表示骨髓中红细胞系增生明显活跃。
(二)造血系统恶性疾患或骨髓转移性肿瘤:见于各种急、慢性白血病及红白血病。由于骨髓中大量白血病细胞充斥而排挤释放幼红细胞,也可因髓外造血缺乏控制能力所致,有核红细胞以中、晚幼红细胞为主。在红白血病时,则可见到更早阶段的红细胞,且伴有形态上有巨幼样变及其他畸变的有核红细胞。
(三)慢性骨髓增生疾病: 骨髓纤维化使有核红细胞来自髓外造血和纤维化的骨髓。骨髓纤维化时,脾、肝、淋巴结等组织恢复胚胎时期的造血功能,这些组织因缺乏对血细胞释放的调控能力,幼稚血细胞大量进入外周血。各发育阶段的幼红细胞都可见到,并可见到幼稚粒细胞及巨核细胞。
二、肿瘤化疗病人血液中易出现NRBC(有核红细胞)。
三、其他疾病:文献报道[1]肺疾患(心功能、呼吸功能衰竭)、菌血症、败血症、烧伤、尿毒症、糖尿病性酸中毒、炎性肠病、心肌梗死、肝脏疾病和肾上腺增生等疾病,造血因子等细胞因子治疗等。
因细胞分析仪在计数白细胞时均将NRBC记在WBC(白细胞)之内,故NRBC增多时可显著影响白细胞计数,使WBC假性增高。我科的XN2000可在排除脂血干扰后自动计数NRBC,校正后准确计数出白细胞数量[2]。一般情况下,对于NRBC计数较低的标本(<0.5×109/L),不会产生有明显临床意义的影响,当NRBC计数明显增高(>1.0×109/L)时,可使WBC明显增高,应报告减去NRBC的WBC更为准确。
有核红细胞的临床应用
一、很多放化疗的病人长期用药后会出现白细胞总数很低且外周血伴有NRBC(提示髓外造血)若此时未发现很低的白细胞总数中有NRBC就会对医生有严重误导,NRBC能准确计数出来并校正WBC总数。
二、评价地中海贫血治疗疗效,重型地中海贫血外周血可出现中、晚幼红细胞。
三、血液科患者手术后,外周血存在NRBC的患者死亡率达到21.1%且含量越高死亡率越高,而不存在者的死亡率仅为1.2%。
四、外周血存在NRBC的患者进行骨髓移植的预后较差,其移植死亡率和NRBC浓度成正比,当外周血中NRBC达到0.2x109L时,死亡率为100%。
注:三、四数据来源于无锡医院中心实验室及血液科对100例不同年龄段患者的血片中出现有核红细胞的病例进行观察,该100例均为未治疗的初诊病人,后经临床诊断疾病类型。
影响因素近期服用过避孕药、甲状腺激素等药物可能会影响到检查结果。
参考文献
1.Wang FS,Itose Y,Tsuji T,et al. Development and clinical application of nucleated red blood cell counting and staging on the automated haematology analyzer XE-2100.Clin Lab Heam,2003,25;17-23。
2.《中华检验医学杂志》2005年6月第28卷第6期
文/图:齐霁(检验科)
编辑:董媛媛 闫紫薇